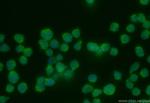
PIK3R2 Antibody in Immunocytochemistry (ICC/IF)

Search
Proteintech
PIK3R2 Recombinant Rabbit Monoclonal Antibody (240531B5)
{{$productOrderCtrl.translations['antibody.pdp.commerceCard.promotion.promotions']}}
{{$productOrderCtrl.translations['antibody.pdp.commerceCard.promotion.viewpromo']}}
{{$productOrderCtrl.translations['antibody.pdp.commerceCard.promotion.promocode']}}: {{promo.promoCode}} {{promo.promoTitle}} {{promo.promoDescription}}. {{$productOrderCtrl.translations['antibody.pdp.commerceCard.promotion.learnmore']}}
产品信息
83606-5-RR
种属反应
宿主/亚型
Expression System
分类
类型
克隆号
抗原
偶联物
形式
浓度
纯化类型
保存液
内含物
保存条件
运输条件
产品详细信息
Immunogen sequence:
YRHESLAQY NAKLDTRLLY PVSKYQQDQI VKEDSVEAVG AQLKVYHQQY QDKSREYDQL YEEYTRTSQE LQMKRTAIEA FNETIKIFEE QGQTQEKCSK EYLERFRREG NEKEMQRILL NSERLKSRIA EIHESRTKLE QQLRAQASDN REIDKRMNSL KPDLMQLRKI RDQYLVWLTQ KGARQKKINE WLGIKNETED QYALMEDEDD LPHHEERTWY VGKINRTQAE EMLSGKRDGT FLIRESSQRG CYACSVVVDG DTKHCVIYRT ATGFGFAEPY NLYGSLKELV LHYQHASLVQ HNDALTVTLA HPVRAPGPGP PPAAR
靶标信息
Binds to activated (phosphorylated) protein-tyrosine kinases, through its SH2 domain, and acts as an adapter, mediating the association of the p110 catalytic unit to the plasma membrane.
仅用于科研。不用于诊断过程。未经明确授权不得转售。
篇参考文献 (0)
生物信息学
蛋白别名: Phosphatidylinositol 3-kinase 85 kDa regulatory subunit beta; phosphatidylinositol 3-kinase regulartory subunit polypeptide 2; Phosphatidylinositol 3-kinase regulatory subunit beta; phosphatidylinositol 3-kinase, regulartory subunit, polypeptide 2; phosphatidylinositol 3-kinase, regulatory subunit, polypeptide 2 (p85 beta); phosphoinositide-3-kinase regulatory subunit beta; phosphoinositide-3-kinase, regulatory subunit 2 (beta); PI3-kinase p85 subunit beta; PI3-kinase regulatory subunit beta; PI3-kinase subunit p85-beta; PI3K; PI3K regulatory subunit beta; ptdIns-3-kinase p85-beta; ptdIns-3-kinase regulatory subunit beta; ptdIns-3-kinase regulatory subunit p85-beta
基因别名: MPPH; MPPH1; p85; p85-BETA; P85B; PIK3R2
UniProt ID: (Human) O00459
Entrez Gene ID: (Human) 5296, (Rat) 29741